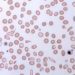
Crizanlizumab use lowers rates of sickle cell crises

Addition of ticagrelor to aspirin significantly increased graft patency after elective CABG
1. In this randomized controlled trial, saphenous vein graft patency after elective CABG was significantly improved in patients treated with ticagrelor plus aspirin versus aspirin alone after one year.
2. There was no significant difference in improvement in graft patency between ticagrelor and aspirin monotherapies.
Evidence Rating: 1 (Excellent)
Study Rundown: The majority of patients who undergo CABG receive saphenous vein grafts (SVGs), and antiplatelet therapy with aspirin improves vein graft patency. While dual antiplatelet therapy with aspirin (DAPT) and a P2Y12 receptor antagonist (clopidogrel, prasugrel, or ticagrelor) improves outcomes in patients with acute coronary syndrome, the effect of DAPT in the setting of CABG has not been confirmed. In this open-label RCT, treatment with ticagrelor plus aspirin was superior to aspirin alone in maintaining SVG patency up to 1 year after elective CABG. There was no significant differences in SVG patency between aspirin and ticagrelor monotherapies. The incidence of major adverse cardiovascular events (MACE) and major bleeding was low in all groups whereas minimal bleeding episodes occurred more frequently in patients treated with combination therapy.
This adequately powered study does provide evidence to show that DAPT has improved SVG patency at 1 year post-CABG with minimal complications. However, the effect of increased graft patency does not answer whether there are also clinically improved patient outcomes, such as reduction in mortality or angina pain. Other limitations include the open-label design, as both investigators and patients were not blinded, the inability to extrapolate results to arterial grafts which are known to be superior to vein grafts in terms of long-term survival and patency rates, and the lack of sufficient power to rule out a significant difference in the incidence of MACE or other secondary bleeding end points.
Click to read the study, published in JAMA
Relevant Reading: DAPT, CABG, and assessing clinical outcomes in addition to SVG patency
In-Depth [randomized controlled trial]: This study examined 500 patients with 1460 saphenous vein grafts. Major exclusion criteria included urgent revascularization or other concomitant cardiac surgery, a need for DAPT or vitamin K antagonist therapy post-CABG, and serious bleeding risk (i.e. history of intracranial hemorrhage, bleeding diathesis within 3 months, or gastrointestinal bleeding within 1 year). The SVG patency rate at 1 year after elective CABG was 88.7% (432/487 grafts) in patients treated with ticagrelor plus aspirin, 82.8% (404/488 grafts) in patients treated with ticagrelor alone, and 76.5% (371/485 grafts) in patients treated with aspirin alone. The difference in SVG patency rate at 1 year for combination therapy vs aspirin alone was statistically significant (12.2%; CI95 5.2-19.2%]). The difference between ticagrelor and aspirin monotherapies was not statistically significant (6.3%; CI95 -1.1%-13.7%). 16 MACEs were observed during 1 year follow-up including 3 in the combination group, 4 in the ticagrelor alone group, and 9 in the aspirin alone group. 5 patients experienced major bleeding, including 3 patients in the combination group and 2 patients in the ticagrelor alone group. Non-CABG related bleeding was 30% (51/168) in the combination group, 12.1% (20/166) in the ticagrelor alone group, and 9% (15/166) in the aspirin alone group, the majority of which were due to minimal bleeding most commonly in the skin, nose, and mouth. The magnitude of the difference observed between combination treatment vs aspirin alone translates into a number needed to treat of 8.
Image: PD
©2018 2 Minute Medicine, Inc. All rights reserved. No works may be reproduced without expressed written consent from 2 Minute Medicine, Inc. Inquire about licensing here. No article should be construed as medical advice and is not intended as such by the authors or by 2 Minute Medicine, Inc.